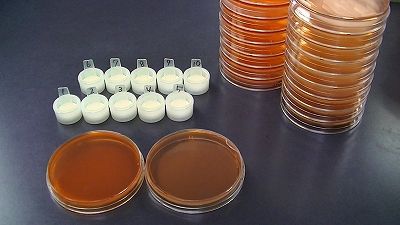
拭き取り検査

大人気!桔梗信玄餅包装体験
ここ笛吹市にある桔梗屋工場テーマパークでは、包装体験というイベントを毎日行っています。
どんな体験かといいますと、いたってシンプル。
桔梗信玄餅を風呂敷で包む作業をお客様自身で行っていただく体験なのです。
スタッフの説明を聞きながら、4個の桔梗信玄餅を包むのですが上手く包むのは意外に難しい。
でも、自分でひとつひとつ真剣に包んだ桔梗信玄餅はとても愛着がありますね。
もちろん、包装した桔梗信玄餅は専用の箱に入れてお土産にお持ち帰り出来ます。
工場テーマパーク限定のイベントで、早い時間に定員数を超えて終了してしまうほど大人気です。
お子様も参加OKなので、旅の楽しい思い出になりますよ。
byのむら
拭き取り検査
先日ご紹介した検査のほかに、
毎月、拭き取り検査というものも行っています。
工場内や直営店の厨房が、清潔に保たれているか
こちらのキットを使って検査しています。
各課、各直営店へ行き、
番号をふったスタンプで、気になる箇所をふきふきしてきます。
そして、回収してきたスタンプを培地に塗抹し、2日間培養します。
主に大腸菌群と黄色ブドウ球菌の検査をしているのですが、
こちらの培地もよく似た色をしているので、間違えないよう要注意です。
どちらも、いたら大変な細菌なので、
キレイな環境で作業が行われているか、厳しくチェックしています。
たけ
空中落下菌検査
9月は雨続きでじめじめした空気になる日が多い月でした。
先日、やっと顔を出すようになった太陽に嬉しくなったという
人も多いと思います。
こんな風に雨の続く季節に気になるのはカビです。
品質管理室では毎月、抜き打ちで工場内の空中に浮遊しているカビや
一般生菌(常温で繁殖する細菌)を検査しています。

どうやるかというと、調べたい場所、主に従業員の通行が多い場所や
お菓子製造時、特によく使用する場所(作業台など)に写真のように
培地を置きます。カビをキャッチする培地と一般生菌をキャッチする
培地が各2枚ずつです。
色がそっくりなので、培地を作るときはうっかり混ざってしまわないように
印をつけておきます。
そして、それぞれ決まった時間分、検査場所で蓋を開けて空気中に
存在している菌を採取、培養して計測します。
品質管理室では毎日のお菓子の細菌検査だけではなく、
こういった衛生検査を厳しい目でおこなって、食の安全の厳守に努めています。
お客様に気持ち良く、美味しいお菓子を召し上がっていただくために
今日も張り切って仕事をこなします。
製造部 土橋
